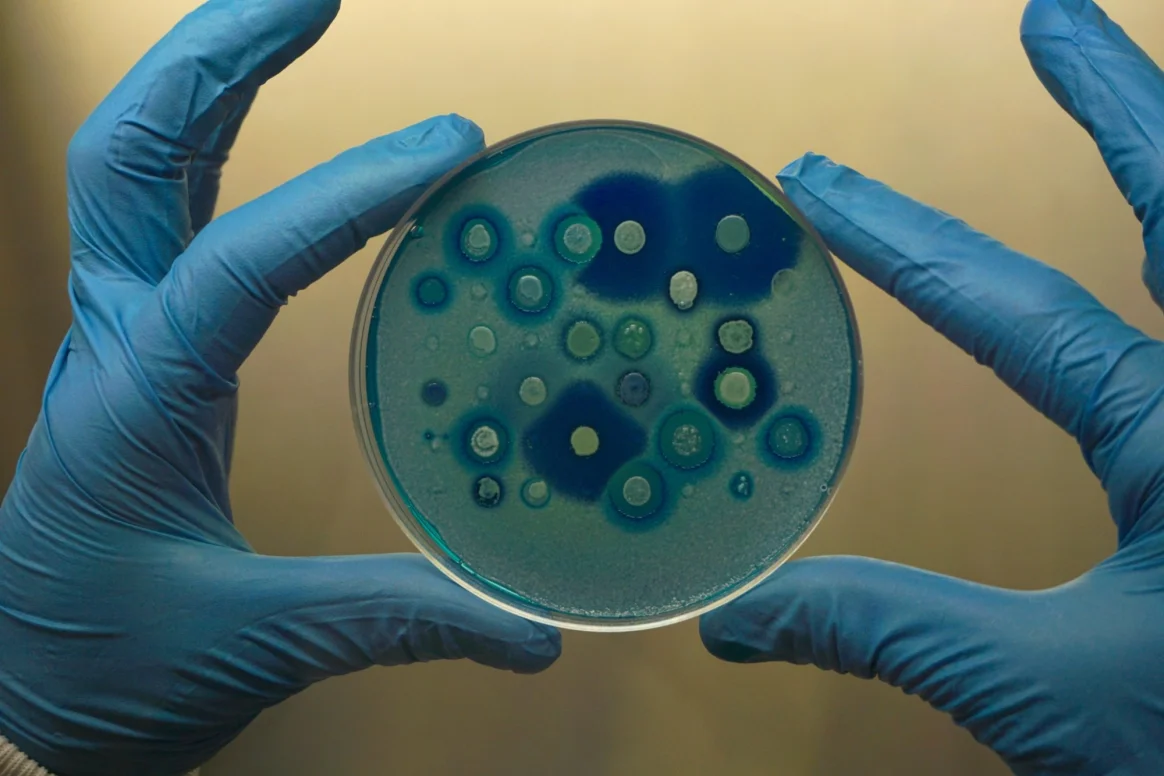

كشفت دراسة حديثة أجريت بجامعة “ماكماستر” الكندية، عن مادة حيوية قادرة على إضعاف الفطريات المقاومة للأدوية وإعادة فاعلية بعض العلاجات التقليدية التي فقدت تأثيرها، خصوصًا لدى أصحاب المناعة الضعيفة.
وأوضحت الدراسة المنشورة بالموقع الرسمي للجامعة، أن المادة المكتشفة المعروفة باسم Butyrolactol A، لا تعمل على قتل الفطريات بشكل مباشر، بل تستهدف آلية داخلية حيوية في الخلية الفطرية، ما يؤدي إلى إرباك بنيتها وإضعاف قدرتها على مقاومة الأدوية المضادة للفطريات.
وبيّنت أن هذه المادة تعطل بروتينات مسؤولة عن تنظيم الدهون في غشاء الخلية الفطرية، الأمر الذي يجعل الغشاء أقل كفاءة وأكثر قابلية لاختراق الأدوية، وهو ما يسمح بإعادة تفعيل مضادات فطرية كانت غير فعالة سابقًا، خاصة ضد أنواع خطيرة مثل Cryptococcus وCandida auris.وفق “أخبار 24”.
ويفتح هذا الاكتشاف مسارًا علاجيًا جديدًا يعتمد على تعطيل مقاومة الفطر نفسه بدلًا من تطوير أدوية جديدة بالكامل، وهي استراتيجية قد تسهم في الحد من انتشار الفطريات المقاومة وتحسين فرص علاج العدوى الفطرية المهدِّدة للحياة مستقبلاً.